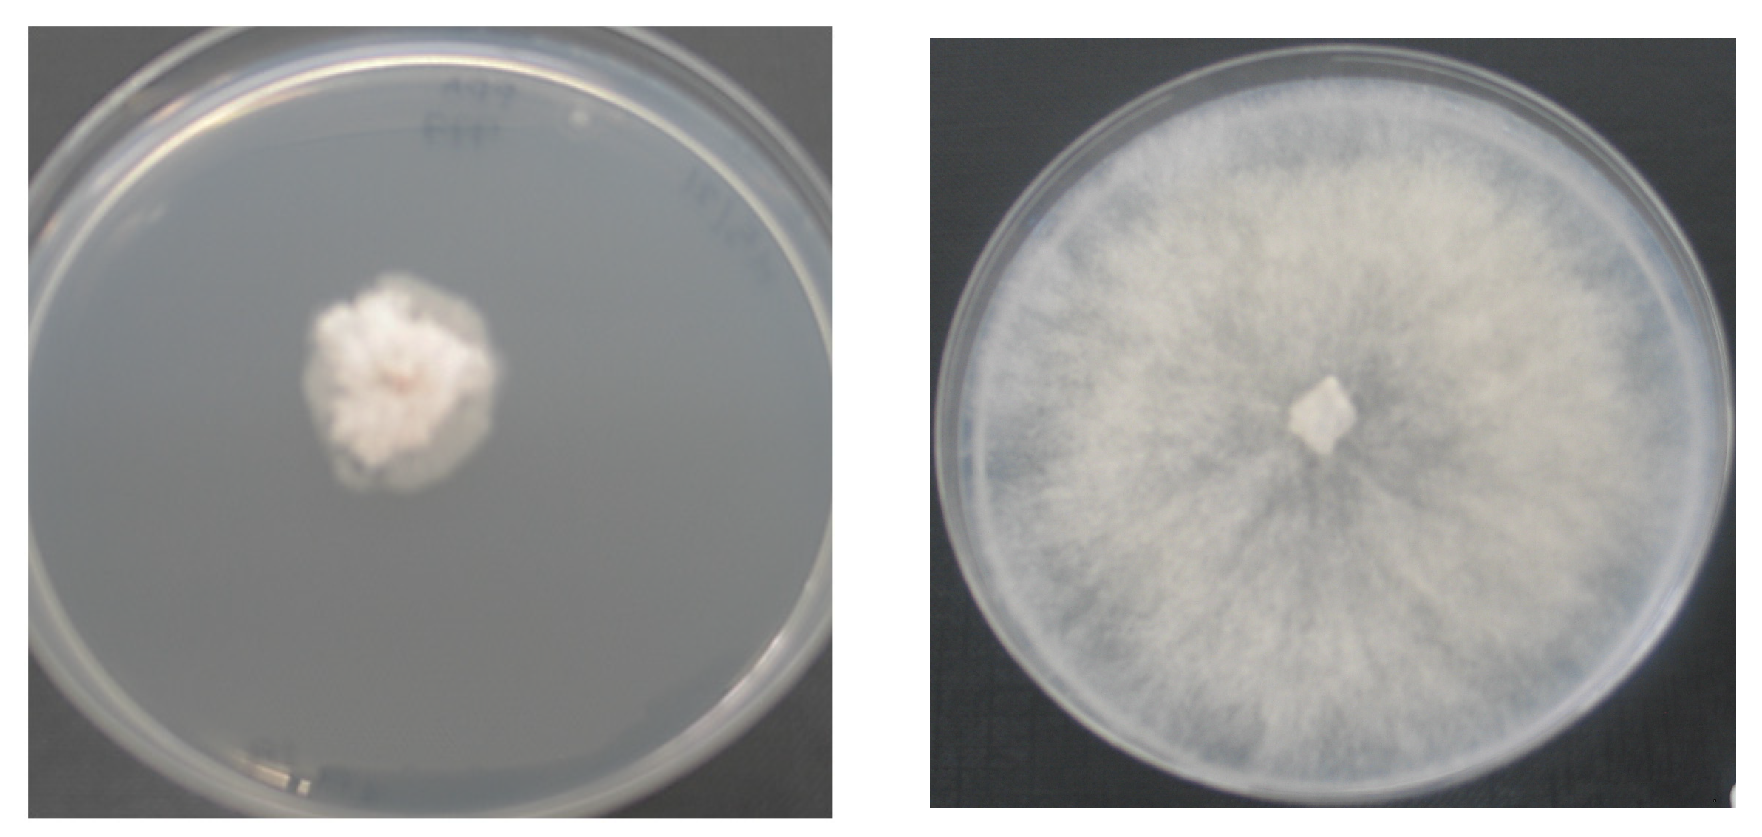
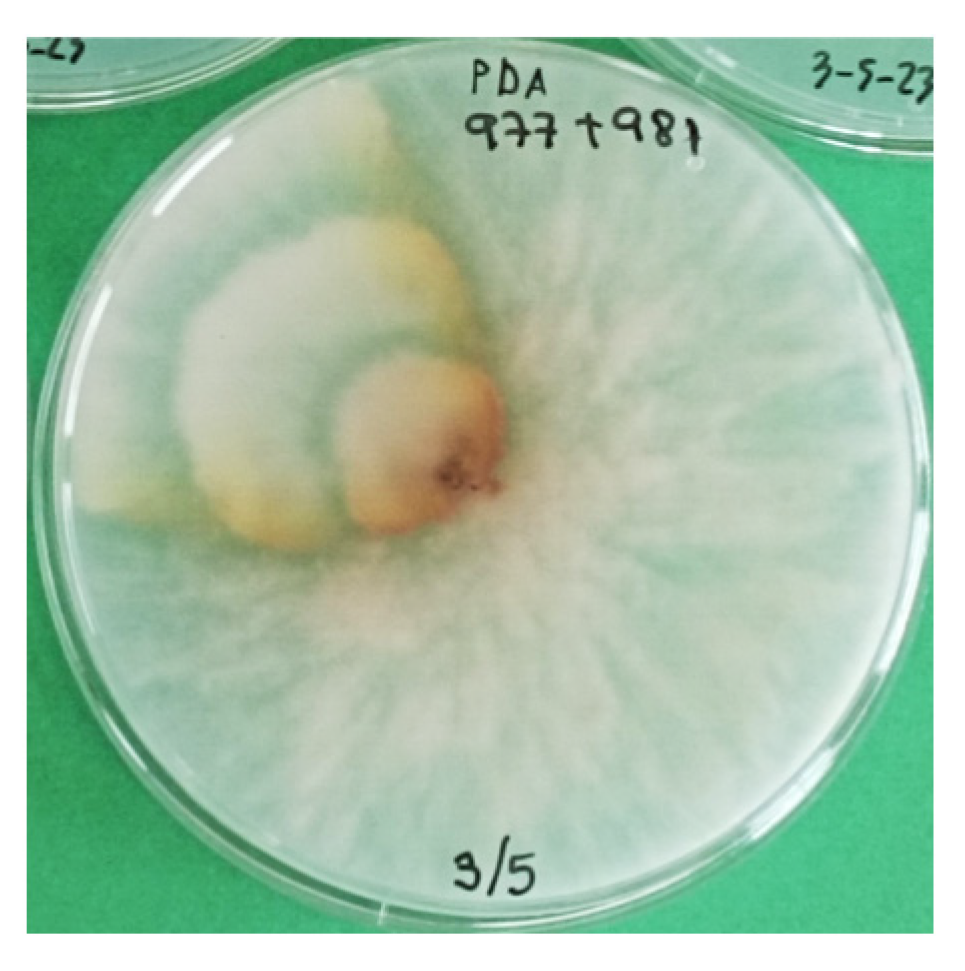

Shoot Dieback in Thornless Blackberries in Northern Spain Caused by Diaporthe rudis and Gnomoniopsis idaeicola
Abstract
1. Introduction
2. Materials and Methods
2.1. Sample Analysis
2.2. Identification
2.3. Multigen Analysis
2.4. Pathogenicity Tests
2.5. Statistical Analysis
3. Results
3.1. Pathogen Isolation
3.2. Morphological Characteristics
3.3. Identification
3.4. Multigen Analysis
3.5. Pathogenicity
4. Discussion
Supplementary Materials
Author Contributions
Funding
Data Availability Statement
Acknowledgments
Conflicts of Interest
References
- Clark, J.R.; Finn, C.E. Blackberry breeding and genetics. In Methods in Temperate Fruit Breeding. Fruit, Vegetable, and Cereal Science and Biotechnology; Flachowsky, H., Hanke, V.M., Eds.; Global Science Books, Ltd.: East Sussex, UK, 2011; pp. 27–43. [Google Scholar]
- Jennings, D.L. Raspberry and Blackberries: Their Breeding, Diseases and Growth; Academic Press: San Diego, CA, USA, 1988; 230p. [Google Scholar]
- Clark, J.R.; Moore, J.N.; Lopez-Medina, J.; Finn, C.; Perkins-Veazie, P. ‘Prime-Jan’ (‘APF-8’) and ‘Prime-Jim’ (‘APF-12’) primocane-fruiting blackberries. HortScience 2005, 40, 852–855. [Google Scholar] [CrossRef]
- Ding, M.; Feng, R.; Wang, S.Y.; Bowman, L.; Lu, Y.; Qian, Y.; Castranova, V.; Jiang, B.-H.; Shi, X. Cyanidin-3-glucoside, a natural product derived from blackberry, exhibits chemopreventive and chemotherapeutic activity. J. Biol. Chem. 2006, 281, 17359–17368. [Google Scholar] [CrossRef]
- Kaume, L.; Howard, L.R.; Devareddy, L. The Blackberry Fruit: A Review on Its Composition and Chemistry, Metabolism and Bioavailability, and Health Benefits. J. Agric. Food Chem. 2012, 60, 5716–5727. [Google Scholar] [CrossRef] [PubMed]
- Gil-Martínez, L.; Mut-Salud, N.; Ruiz-García, J.A.; Falcón-Piñeiro, A.; Maijó-Ferré, M.; Baños, A.; De la Torre Ramírez, J.M.; Guillamón, E.; Verardo, V.; Gómez-Caravaca, A.M. Phytochemicals determination and antioxidant, antimicrobial, anti-inflamatory and anticancer activities od blackberry fruits. Foods 2023, 12, 1505. [Google Scholar] [CrossRef] [PubMed]
- Memete, A.R.; Sarac, I.; Teusdea, A.C.; Budau, R.; Bei, M.; Vicas, S.I. Bioactive compounds and antioxidant capacity of several blackberry (Rubus spp.) fruits cultivars grown in Romania. Horticulturae 2023, 9, 556. [Google Scholar] [CrossRef]
- Mercado de Bayas Frescas: Crecimiento, Tendencias, Impacto de COVID-19 y Pronósticos (2023–2028). Available online: https://www.mordorintelligence.com/es/industry-reports/fresh-berries-market (accessed on 3 August 2023).
- Ellis, M.A.; Converse, R.H.; Williams, R.N.; Williamson, B. Compendium of Raspberry and Blackberry Diseases and Insects; The American Phytopathological Society: Saint Paul, MN, USA, 1991; 100p. [Google Scholar]
- Vrandecic, K.; Jurkovic, D.; Cosic, J.; Postic, J.; Riccioni, L. First Report of Cane Blight on Blackberry Caused by Diaporthe eres in Croatia. Plant Dis. 2011, 95, 612. [Google Scholar] [CrossRef]
- Mirhosseini, H.A.; Rahimian, H.; Babaeizad, V.; Hashemi, L. Outbreak of leafspot on blackberry (Rubus fruticosus) caused by Gnomoniopsis sp. in Iran. New Dis. Rep. 2015, 31, 9. [Google Scholar] [CrossRef]
- Stevanović, M.; Ristić, D.; Živković, S.; Aleksić, G.; Stanković, I.; Krstić, B.; Bulajić, A. Characterization of Gnomoniopsis idaeicola, the causal agent of canker and wilting of blackberry in Serbia. Plant Dis. 2019, 103, 249–258. [Google Scholar] [CrossRef]
- Stockwell, V.O.; Shaffer, B.T.; McGhee, G.C.; Hardigan, M.A. First report of Gnomoniopsis idaeicola causing cane wilt and canker in commercial blackberry fields in Oregon. Plant Dis. 2022, 106, 1980. [Google Scholar] [CrossRef]
- Udayanga, D.; Liu, X.; McKenzie, E.H.C.; Chukeatirote, E.; Bahkali, A.H.A.; Hyde, K.D. The genus Phomopsis: Biology, applications, species concepts and names of common phytopathogens. Fungal Divers. 2011, 50, 189–225. [Google Scholar] [CrossRef]
- Gomes, R.R.; Glienke, C.; Videira, S.I.R.; Lombard, L.; Groenewald, J.Z.; Crous, P.W. Diaporthe: A genus of endophytic, saprobic and plant pathogenic fungi. Persoonia 2013, 31, 1–41. [Google Scholar] [CrossRef] [PubMed]
- Dissanayake, A.J.; Camporesi, E.; Hyde, K.D.; Zhang, W.; Yan, J.Y.; Li, X.H. Molecular phylogenetic analysis reveals seven new Diaporthe species from Italy. Mycosphere 2017, 8, 853–877. [Google Scholar] [CrossRef]
- Dissanayake, A.J.; Phillips, A.J.L.; Hyde, K.D.; Yan, J.Y.; Li, X.H. The current status of species in Diaporthe. Mycosphere 2017, 8, 1106–1156. [Google Scholar] [CrossRef]
- Marin-Felix, Y.; Hernández-Restrepo, M.; Wingfield, M.J.; Akulov, A.; Carnegie, A.J.; Cheewangkoon, R.; Gramaje, D.; Groenewald, J.Z.; Guarnaccia, V.; Halleen, F.; et al. Genera of phytopathogenic fungi: GOPHY 2. Stud. Mycol. 2019, 92, 47–133. [Google Scholar] [CrossRef]
- Walker, D.M.; Castlebury, L.A.; Rossman, A.Y.; Sogonov, M.V.; White, J.F. Systematics of genus Gnomoniopsis (Gnomoniaceae, Diaporthales) based on a three gene phylogeny, host associations and morphology. Mycologia 2010, 102, 1479–1496. [Google Scholar] [CrossRef] [PubMed]
- Thomidis, T.; Michailides, T.J. Studies on Diaporthe eres as a new pathogen of peach trees in Greece. Plant Dis. 2009, 93, 1293–1297. [Google Scholar] [CrossRef] [PubMed]
- Bai, Q.; Zhai, L.F.; Chen, X.R.; Hong, N.; Xu, W.X.; Wang, G.P. Biological and molecular characterization of five Phomopsis species associated with pear shoot canker in Chine. Plant Dis. 2015, 99, 1704–1712. [Google Scholar] [CrossRef]
- Zhang, Q.M.; Yu, C.L.; Li, G.F.; Wang, C.X. First report of Diaporthe eres causing twig canker on Zizyphus jujuba (Jujube) in China. Plant Dis. 2018, 102, 1458. [Google Scholar] [CrossRef]
- White, T.J.; Bruns, T.D.; Lee, S.B.; Taylor, J.W. Amplification and direct sequencing of fungal ribosomal RNA Genes for phylogenetics. In PCR—Protocols and Applications—A Laboratory Manual; Innis, M.A., Gelfand, D.H., Sninsky, J.J., White, T.J., Eds.; Academic Press Inc.: New York, NY, USA, 1990; pp. 315–322. [Google Scholar]
- Glass, N.L.; Donaldson, G.C. Development of primers sets designed for use with the PCR to amplify conserved genes from filamentous ascomycetes. Appl. Environ. Microbiol. 1995, 61, 1323–1330. [Google Scholar] [CrossRef]
- Carbone, I.; Kohn, L.M. A method for designing primer sets for speciation studies in filamentous ascomycetes. Mycologia 1999, 91, 553–556. [Google Scholar] [CrossRef]
- Crous, P.W.; Groenewald, J.Z.; Risède, J.-M.; Simoneau, P.; Hywel-Jones, N.L. Calonectria species and their Cylindrocladium anamorphs: Species with sphaeropedunculate vesicles. Stud. Mycol. 2004, 50, 415–430. [Google Scholar]
- Udayanga, D.; Castlebury, L.A.; Rossman, A.Y.; Hyde, K.D. Species limits in Diaporthe, molecular re-assessment of D. citri, D. cytosporella, D. foeniculina and D. rudis. Persoonia 2014, 32, 83–101. [Google Scholar] [CrossRef] [PubMed]
- Thompson, J.D.; Higgins, D.G.; Gibson, T.J. CLUSTAL W: Improving the sensitivity of progressive multiple sequence alignment through sequence weighting, position-specific gap penalties and weight matrix choice. Nucleic Acids Res. 1994, 22, 4673–4680. [Google Scholar] [CrossRef] [PubMed]
- Tamura, K.; Nei, M. Estimation of the number of nucleotide substitutions in the control region of mitochondrial DNA in humans and chimpanzees. Mol. Biol. Evol. 1993, 10, 512–526. [Google Scholar]
- Tamura, K.; Stecher, G.; Kumar, S. MEGA 11: Molecular Evolutionary Genetics Analysis Version 11. Mol. Biol. Evol. 2021, 38, 3022–3027. [Google Scholar] [CrossRef]
- Tajima, F. Statistical methods to test for nucleotide mutation hypothesis by DNA polymorphism. Genetics 1989, 123, 585–595. [Google Scholar] [CrossRef]
- Jiang, N.; Voglmayr, H.; Bian, D.-R.; Piao, C.-G.; Wang, S.-K.; Li, Y. Morphology and Phylogeny of Gnomoniopsis (Gnomoniaceae, Diaporthales) from Fagaceae Leaves in China. J. Fungi 2021, 7, 792. [Google Scholar] [CrossRef]
- Index Fungorum. Available online: http://indexfungorum.org/Names/Names.asp (accessed on 8 November 2022).
- Guarnaccia, V.; Martino, I.; Tabone, G.; Brondino, L.; Gullino, M.L. Fungal pathogens associated with stem blight and dieback of blueberry in northern Italy. Phytopathol. Mediterr. 2020, 59, 229–245. [Google Scholar] [CrossRef]
- Santos, L.; Alves, A.; Alves, R. Evaluating multi-locus phylogenies for species boundaries determination in the genus Diaporthe. PeerJ. 2017, 5, e3120. [Google Scholar] [CrossRef]
- Guarnaccia, V.; Groenewald, J.Z.; Woodhall, J.; Armengol, J.; Cinelli, T.; Eichmeier, A.; Ezra, D.; Fontaine, F.; Gramaje, D.; Gutierrez-Aguirregabiria, A.; et al. Diaporthe diversity and pathogenicity revealed from a broad survey of grapevine diseases in Europe. Persoonia 2018, 40, 135–153. [Google Scholar] [CrossRef]
- Hilario, S.; Amaral, I.A.; Gonçalves, M.F.M.; Lopes, A.; Santos, L.; Alves, A. Diaporthe species associated with twig blight and dieback of Vaccinium corymbosum in Portugal, with description of four new species. Mycologia 2020, 112, 293–308. [Google Scholar] [CrossRef] [PubMed]
- León, M.; Berbegal, M.; Rodríguez-Reina, J.M.; Elena, G.; Abad-Campos, P.; Ramón-Albalat, A.; Olmo, D.; Vicent, A.; Luque, J.; Miarnau, X.; et al. Identification and characterization of Diaporthe spp. associated with twig cankers and shoot blight of almonds in Spain. Agronomy 2020, 10, 1062. [Google Scholar] [CrossRef]
- Santos, J.M.; Correia, V.G.; Phillips, A.J.L. Primers for mating-type diagnosis in Diaporthe and Phomopsis: Their use in teleomorph induction in vitro and biological species definition. Fungal Biol. 2010, 114, 255–270. [Google Scholar] [CrossRef] [PubMed]
- UK Plant Health Risk Register. Available online: https://planthealthportal.defra.gov.uk/pests-and-diseases/uk-plant-health-risk-register/viewPestRisks.cfm?cslref=30313&riskId=28102 (accessed on 8 February 2023).
- Comby, M.; Lacoste, S.; Baillieul, F.; Profizi, C.; Dupont, J. Spatial and temporal variation of cultivable communities of co-occurring endophytes and pathogens in wheat. Front. Microbiol. 2016, 7, 403. [Google Scholar] [CrossRef]
- Adams, S.J.; Robicheau, B.M.; LaRue, D.; Browne, R.D.; Walker, A.K. Foliar Endophytic Fungi from the Endangered Eastern Mountain Avens (Geum peckii, Rosaceae) in Canada. Plants 2021, 10, 1026. [Google Scholar] [CrossRef]
- Dominguez-Moñino, I.; Jurado, V.; Rogerio-Candelera, M.A.; Hermosin, B.; Saiz-Jimenez, C. Airborne Fungi in Show Caves from Southern Spain. Appl. Sci. 2021, 11, 5027. [Google Scholar] [CrossRef]
- Walther, G.; Zimmermann, A.; Theuersbacher, J.; Kaerger, K.; von Lilienfeld-Toal, M.; Roth, M.; Kampik, D.; Geerling, G.; Kurzai, O. Eye Infections Caused by Filamentous Fungi: Spectrum and Antifungal Susceptibility of the Prevailing Agents in Germany. J. Fungi 2021, 7, 511. [Google Scholar] [CrossRef]
- Torres, C.; Camps, R.; Aguirre, R.; Besoain, X. First report of Diaporthe rudis in Chile causing stem-end rot on ‘Hass’ avocado fruit imported from California. Plant Dis. 2016, 100, 1951. [Google Scholar] [CrossRef]
- KC, A.N.; Rasmussen, A.L. First report of Diaporthe rudis causing fruit rot of European Pears in the United States. Plant Dis. 2019, 103, 2132. [Google Scholar] [CrossRef]
- Díaz, G.A.; Latorre, B.A.; Lolas, M.; Ferrada, E.; Naranjo, P.; Zoffoli, J.P. Identification and characterization of Diaporthe ambigua, D. australafricana, D. novem, and D. rudis causing a postharvest fruit rot in kiwifruit. Plant Dis. 2017, 101, 1402–1410. [Google Scholar] [CrossRef]
- Petrović, K.; Riccioni, L.; Vidić, M.; Đorđević, V.; Balešević-Tubić, S.; Đukić, V.; Miladinov, Z. First report of Diaporthe novem, D. foeniculina, and D. rudis associated with soybean seed decay in Serbia. Plant Dis. 2016, 100, 2324. [Google Scholar] [CrossRef]
- Lorenzini, M.; Zapparoli, G. Diaporthe rudis associated with berry rot of postharvest grapes in Italy. Plant Dis. 2019, 103, 1030. [Google Scholar] [CrossRef]
- Huang, F.; Udayanga, D.; Wang, X.; Hou, X.; Mei, X.; Fu, Y.; Hyde, K.D.; Li, H.Y. Endophytic Diaporthe associated with Citrus: A phylogenetic reassessment with seven new species from China. Fungal Biol. 2015, 119, 331–347. [Google Scholar] [CrossRef] [PubMed]
- Lombard, L.; van Leeuwen, G.; Guarnaccia, V.; Polizzi, G.; van Rijswick, P.; Rosendah, K.; Crous, P. Diaporthe species associated with Vaccinium in Europe. Phytopathol. Mediterr. 2014, 53, 287–299. [Google Scholar]

). Chi-squared analysis is shown for percentage data (***: p < 0.001) (A). Different capital letters indicate significant differences (p < 0.001) among pathogens, according to a posteriori Tukey’s test (B).
). Chi-squared analysis is shown for percentage data (***: p < 0.001) (A). Different capital letters indicate significant differences (p < 0.001) among pathogens, according to a posteriori Tukey’s test (B).

| Gen | Definition | Primers | Primer Sequence | Reference |
|---|---|---|---|---|
| ITS | Internal transcribed spacer | ITS1 ITS4 | TCCGTAGGTGAACCTGCGG TCCTCCGCTTATTGATATGC | [23] |
| tub2 | β-tubulin | Bt2a Bt2b | GGTAACCAAATCGGTGCTGCTTTC ACCCTCAGTGTAGTGACCCTTGGC | [24] |
| tef-1a | Translation elongation factor | EF1-728F EF1-986R | CATCGAGAAGTTCGAGAAGG TACTTGAAGGAACCCTTACC | [25] |
| his | Histone H3 | CYLH3F H3-1bR | AGGTCCACTGGTGGCAAG GCGGGCGAGCTGGATGTCCTT | [26] [24] |
| cal | Calmodulin | CAL-563F CL2AR | GAC AAA TCA CCA CCA ARG AG TTT TTG CAT CAT GAG TTG GA | [27] |
| Gene | m | n | S | π | |
|---|---|---|---|---|---|
| LPPAF-977 | ITS | 31 | 407 | 77 | 0.046049 |
| tub2 | 27 | 354 | 160 | 0.149701 | |
| tef-1a | 29 | 212 | 192 | 0.295439 | |
| ITS + tub2 + tef-1a | 27 | 992 | 425 | 0.143415 | |
| LPPAF-981 | ITS | 211 | 507 | 286 | 0.064820 |
| tub2 | 201 | 440 | 350 | 0.107078 | |
| tef-1a | 191 | 311 | 228 | 0.158144 | |
| his | 142 | 345 | 177 | 0.093925 | |
| ITS + tub2 + tef-1a + his | 137 | 1647 | 817 | 0.097558 |
Disclaimer/Publisher’s Note: The statements, opinions and data contained in all publications are solely those of the individual author(s) and contributor(s) and not of MDPI and/or the editor(s). MDPI and/or the editor(s) disclaim responsibility for any injury to people or property resulting from any ideas, methods, instructions or products referred to in the content. |
© 2023 by the authors. Licensee MDPI, Basel, Switzerland. This article is an open access article distributed under the terms and conditions of the Creative Commons Attribution (CC BY) license (https://creativecommons.org/licenses/by/4.0/).
Share and Cite
González, A.J.; Ciordia, M. Shoot Dieback in Thornless Blackberries in Northern Spain Caused by Diaporthe rudis and Gnomoniopsis idaeicola. Horticulturae 2023, 9, 965. https://doi.org/10.3390/horticulturae9090965
González AJ, Ciordia M. Shoot Dieback in Thornless Blackberries in Northern Spain Caused by Diaporthe rudis and Gnomoniopsis idaeicola. Horticulturae. 2023; 9(9):965. https://doi.org/10.3390/horticulturae9090965
Chicago/Turabian StyleGonzález, Ana J., and Marta Ciordia. 2023. "Shoot Dieback in Thornless Blackberries in Northern Spain Caused by Diaporthe rudis and Gnomoniopsis idaeicola" Horticulturae 9, no. 9: 965. https://doi.org/10.3390/horticulturae9090965
APA StyleGonzález, A. J., & Ciordia, M. (2023). Shoot Dieback in Thornless Blackberries in Northern Spain Caused by Diaporthe rudis and Gnomoniopsis idaeicola. Horticulturae, 9(9), 965. https://doi.org/10.3390/horticulturae9090965

